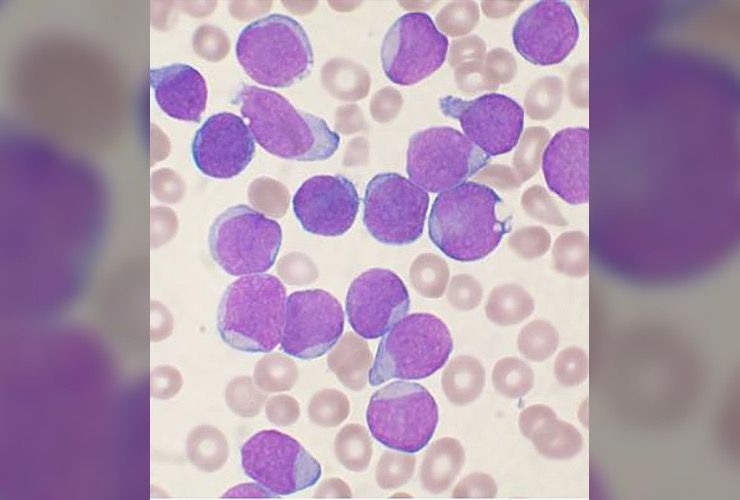
Common Types of Cancer Story

there are far too many forms of cancer to name them all here. The 14 types of cancer represented here are the major types, those which are most commonly found and diagnosed. However, there are many other rare forms of cancer the affect a lesser percentage of the population.
Cancerous Cells
All types of cancer share common markers. This means that cancer cells, which look different from other healthy cells, possess unique characteristics discernible by oncologists and other such experts. These markers include damaged or mutated cells, rapid cell multiplication, and the ability of these damaged cells to spread throughout the body.Many Affected
1. Skin Cancer
Melanoma
Melanoma, on the other hand, allegedly affects 68,720 people and is most commonly found in moles. It’s named for the parts of the body that contain melanocyte cells, those that produce brown pigment, but can be found in other pigmented cells like those in the intestines or even the eyes. Both these skin cancers are treatable and are among the easiest to spot, though they can spread easily.
2. Lung Cancer
Lung cancer strikes at the cells inside the lining of the lungs. There are two primary forms of lung cancer, though both are deadly if found too late. Small cell is named for the small round cancer cells that can be viewed in a microscope. Non-small cell lung cancer cells are slightly larger. Every year, both these types of cancer combined claim nearly 160,000 lives.
3. Breast Cancer
As expected, breast cancer is most commonly diagnosed in women. However, that’s not to say men can’t be diagnosed as well. In fact, there are about 1,900 men diagnosed with breast cancer each year. Treatment for breast cancer usually involves removing the offending breast tissue and tumor, combined with chemotherapy and radiation to halt the spread.
4. Prostate Cancer
Unlike breast cancer, which can affect both men and women, prostate cancer only affects men. More than 190,000 cases of prostate cancer are diagnosed annually. Most of these cases affect men over the age of 50. Prostate cancer develops in the tissues inside the prostate gland, near the rectum. Because of this location, near the colon, it is one of the more spreadable and dangerous cancers.
5. Cervical Cancer
On the opposite end of the spectrum is cervical cancer, which can only affect women; but women of all ages. It accounts for more than 260,000 deaths worldwide, 4,000 of them in the US alone. The cervix is located at the lower end of the uterus which opens into the upper portion of the vaginal canal. It is recommended that women visit the gynecologist and get checked regularly for these cancerous cells.
6. Colorectal Cancer
The colon is part of the large intestine and helps us break down and digest food. At the end of this long, hard-working tube is the rectum. Every year, thousands of people are diagnosed with colorectal cancer, many too late. It usually affects folks over 50 and can spread quickly, which is why doctors recommend annual colonoscopies after celebrating your 50th birthday.
7. Bladder Cancer
Like any other organ, the bladder can be affected by cancer cells that develop within its tissues, which can be caused by high alcohol consumption — as can the liver and the kidneys. The most common type of cancer to affect the bladder is something called transitional cell carcinoma.
8. Liver Cancer
In 2015, liver cancer claimed the lives of 788,000 people worldwide. The liver is responsible for filtering the blood and food we eat. Since the liver processes all of our blood, it can, therefore, be visited by cancer cells if there is cancer elsewhere in the body. Many cancers that spread to the liver end up being fatal.
9. Kidney Cancer
The kidneys also help filter out toxins from the blood and expel those toxins through urination. Cancer can form in the tissues of the kidney ducts, usually affecting people over the age of 40. There is one type of kidney tumor, however, called a “Wilms” tumor, that affects younger children specifically. More than 49,000 people are diagnosed with kidney cancer each year.
10. Esophageal Cancer
Esophageal cancer is commonly referred to as throat cancer, and it takes the lives of 400,000 people each year. If you smoke, drink heavily, or are obese, your chances of developing this life-changing cancer increases greatly. Treatment for this cancer can permanently damage your esophagus, larynx and windpipe.
11. Non-Hodgkin’s Lymphoma
There a number of cancers that affect the blood. Non-Hodgkin’s Lymphoma is one of them, and it affects more than 65,000 people annually. They call it lymphoma because it affects white blood cells, some of which are lymphocytes. There are dozens of different types of non-Hodgkin’s lymphoma that affect people of all ages. The varying types and spreading of the disease can make it hard to treat.
12. Cancer In The Blood
Leukemia basically results in an overproduction of certain kinds of white blood cells. It can be a chronic, slow-growing type of cancer that often begins without being noticed. Unfortunately, once the symptoms begin, they progress rapidly. Because of these factors, leukemia is a difficult cancer to treat effectively.
13. Leukemia
There are four main types of leukemia or “blood cancer.” These types are acute myeloid leukemia, acute lymphocytic leukemia, chronic lymphocytic leukemia, and chronic myeloid leukemia. Many of these cancers form inside bone marrow or in other tissues that form blood cells and are hard to stop at the source because, well … we all need blood to live.
14. Pancreatic Cancer
Pancreatic cancer is one of the most advanced and deadliest cancers. It is usually undetected until the disease has reached an advanced state. It can present itself as abdominal pain, jaundice, or unexplained weight loss. Unfortunately, by the time symptoms are noticed, it may already be too late.